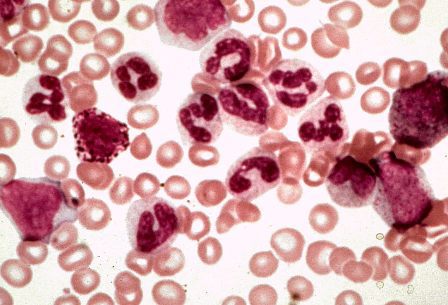

Другие названия и синонимы
D51 Vitamin B12 deficiency anaemia, D51.
Описание
Нет подробного описания, смотрите связи
|
|
Связанные заболевания
Связанные клинические рекомендации
Связанные стандарты мед. помощи
- Стандарт санаторно-курортной помощи больным с болезнями крови, кроветворных органов и отдельными нарушениями, вовлекающими иммунный механизм
- Стандарт первичной медико-санитарной помощи детям при В12-дефицитной анемии (при неустранимой причине дефицита витамина В12)
- Стандарт первичной медико-санитарной помощи детям при В12-дефицитной анемии (при устранимой причине дефицита витамина В12)
- Стандарт специализированной медицинской помощи детям при В12-дефицитной анемии (в дневном стационаре)